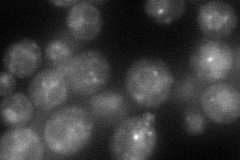
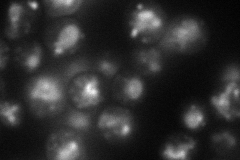
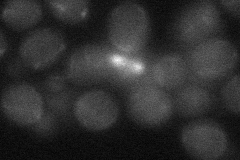
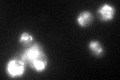

View description
Vacuolar glutathione S-conjugate transporter of the ATP-binding cassette family, has a role in detoxifying metals such as cadmium, mercury, and arsenite; also transports unconjugated bilirubin; similar to human cystic fibrosis protein CFTR
Localization:
Intensity:
Fold change:
Significance:
-
C’ GFP library in SD

vacuole membrane48.79 -
N' NOP1pr-GFP in SD
punctate57.888 -
N' TEF2pr-mCherry in SD
punctate,vacuole70.5487 -
N' NATIVEpr-GFP in SD

ambiguous,punctate30.037 -
N' TEF2pr-VC and Cyto-VN in SD
below threshold23.4804 -
C’ GFP library in SD+DTT
vacuole membrane59.881.22No -
C’ GFP library in SD+H2O2

vacuole membrane52.841.08No -
C’ GFP library in Starvation Media

vacuole membrane89.321.83Yes -
C’ GFP library on the background of Pup2-DaMP

N/A -
C’ GFP library on the background of CCT mutant

N/A0N/AYes
